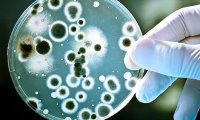
Неуязвимые для антибиотиков бактерии распространяются по планете

Барак Обама назвал своего любимого персонажа из «Игры престолов»
Президент США Барак Обама признался, что сериал «Игра престолов» — одно из его любимых шоу на телевидении. Он рассказал об этом в интервью изданию GQ.

Президент США Барак Обама признался, что сериал «Игра престолов» — одно из его любимых шоу на телевидении. Он рассказал об этом в интервью изданию GQ.

О готовящемся судебном разбирательстве между дизайнерами из Франции и Airbnb сообщает BuzzFeed. Рассмотрение дела о плагиате дизайна главного офиса компании назначено на декабрь.

Летом 1972 года на экраны советских кинотеатров вышел фильм итальянского режиссера Дамиано Дамиани «Следствие закончено, забудьте». Действительность капиталистической Италии предстала по версии...

Канадские исследователи пришли к выводу, что для достижения максимального уровня счастья супругам следует заниматься сексом всего лишь один раз в неделю.

Жители Соединенного Королевства - 103-летний Джордж Кирби и 91-летняя Дорин Лаки попали в Книгу рекордов Гиннесса как самые старые молодожены на планете.

Ирак в борьбе за долю на нефтяном рынке прибегнул к демпингу, в результате чего стоимость нефти из корзины ОПЕК стала минимальной за последние десять лет.

Российский путешественник-инвалид Игорь Скикевич проехал боле 21 тысяч километров автостопом по России от Черного моря до побережья Тихого океана и острова Сахалин.

Федеральная служба государственной статистики (Росстат) опубликовала данные о доходах граждан России за октябрь. По большинству параметров отмечено снижение.

Итальянские археологи обнаружили могилу девушки-подростка, которая обладает всеми признаками захоронения ведьм. Девушка похоронена лицом вниз, а ее могила засыпана камнями.

В четверг в Каире Россия и Египет подписали межправительственное соглашение о сотрудничестве в сооружении по российским технологиям и эксплуатации первой египетской АЭС.
В Китае нашли ген, отвечающий за неуязвимость к колистину — антибиотику из класса полимиксинов, которые считаются антибиотиками «последнего рубежа»: их применяют, когда другие классы препаратов уже...

Создана первая в мире инсулиновая таблетка. Об этом заявили американские ученые университета Санта-Барбары. Таблетка заменит диабетикам инъекции гормона, которые они делают по семь раз в день. И...

Психологи из Университета штата Мичиган изучили реакцию молодых женщин на БДСМ-отношения между героями Анастейшей Стил и Кристианом Греем из фильма «Пятьдесят оттенков серого».

«Век» продолжает следить за ситуацией, складывающейся вокруг телекоммуникационной компании Vivacom, владельцем 76% акций которой является российский бизнесмен Дмитрий Косарев. Сегодня мы публикуем...

Мосгорсуд отказался снять арест с недвижимости, банковских счетов и украшений бывшей чиновницы Минобороны РФ Евгении Васильевой, передает РИА Новости в четверг, 19 ноября.

Volkswagen решил отозвать в России почти две тысячи автомобилей Jetta, Golf и Beetle. Причина — вероятность разрушения в двигателе механизма газораспределения, сообщил Росстандарт.

Эксперт по дизайну интерьера Деборы Нидлман дал рекомендации, как быстро и без особых затрат привести свою квартиру в полный порядок. Особенно это актуально накануне праздников.

Российское антидопинговое агентство (РУСАДА) заявило, что продолжит свою деятельность на территории РФ в том формате, который будет согласован с Всемирным антидопинговым агентством (ВАДА).

Недавно стартовал новый сезон популярного американского телесериала об ученых «Теория большого взрыва. Исполнительный продюсер этого проекта поделился деталями сюжета новых эпизодов.

Известный американский астрофизик и популяризатор науки Нил деГрасс Тайсон ответил на вопрос о том, как проходит секс в космосе и как преодолеть воздействие невесомости.